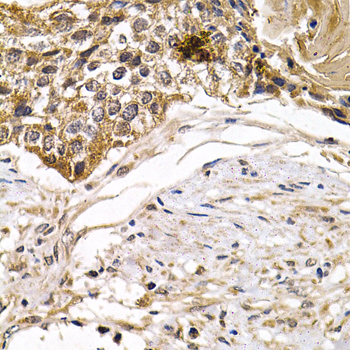

For quotations, please use our online quotation form, and you may also contact us by
sales@neoscientific.com
+1-888.733.6849
+1-617.299.7367 (Int’l)
+1-888.733.6849
+1-617.299.7367 (Int’l)
| Reactivity | Human Mouse Rat |
| Tested applications | WB IHC IF |
| Recommended Dilution | WB 1:500 - 1:2000 IHC 1:50 - 1:200 IF 1:50 - 1:200 |
| Calculated MW | 46kDa |
| Observed MW | Refer to Figures |
| Immunogen | A synthetic Peptide of human ARRB2 |
| Storage Buffer | Store at -20℃. Avoid freeze / thaw cycles. Buffer: PBS with 0.02% sodium azide, 50% glycerol, pH7.3. |
| Concentration | m |
| Synonym | ARRB2;ARB2;ARR2;BARR2;DKFZp686L0365 ;Beta Arrestin 2 |

Western blot analysis of RAW264.7 cell lysate using ARRB2 antibody.
Immunohistochemistry of paraffin-embedded human breast cancer using ARRB2 antibody at dilution of 1:200 (400x lens).

Immunohistochemistry of paraffin-embedded human normal colon using ARRB2 antibody at dilution of 1:200 (400x lens).

Immunohistochemistry of paraffin-embedded human kidney cancer using ARRB2 antibody at dilution of 1:200 (400x lens).

Immunohistochemistry of paraffin-embedded human stomach cancer using ARRB2 antibody at dilution of 1:200 (400x lens).

Immunofluorescence analysis of U20S cell using ARRB2 antibody. Blue: DAPI for nuclear staining.
Arrestin proteins function as negative regulators of G protein-coupled receptor (GPCR) signaling. Cognate ligand binding stimulates GPCR phosphorylation, which is followed by binding of arrestin to the phosphorylated GPCR and the eventual internalization of the receptor and desensitization of GPCR signaling (1). Four distinct mammalian arrestin proteins are known. Arrestin 1 (also known as S-arrestin) and arrestin 4 (X-arrestin) are localized to retinal rods and cones, respectively. Arrestin 2 (also known as β-arrestin 1) and arrestin 3 (β-arrestin 2) are ubiquitously expressed and bind to most GPCRs (2). β-arrestins function as adaptor and scaffold proteins and play important roles in other processes, such as recruiting c-Src family proteins to GPCRs in Erk activation pathways (3,4). β-arrestins are also involved in some receptor tyrosine kinase signaling pathways (5-8). Additional evidence suggests that β-arrestins translocate to the nucleus and help regulate transcription by binding transcriptional cofactors (9,10).
N/A